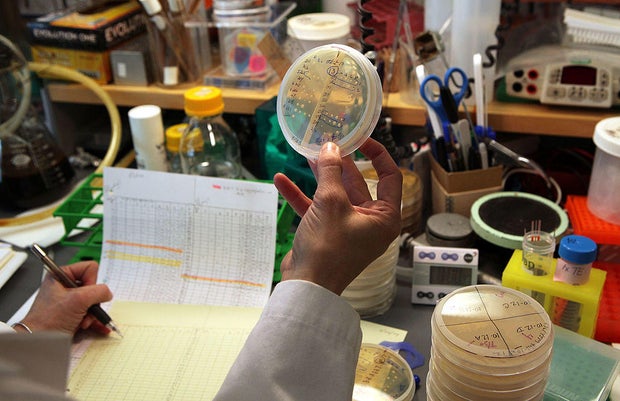
Three American Scientists Share Nobel Prize In Medicine

U.S. jobs most held by immigrants, ranked
At last count, 28.2 million people, representing 17.4 percent of America's employed workforce, was made up of foreign-born people, including immigrants, according to the U.S. Department of Labor.
Where do these millions of people work? Here's the breakdown on the 22 job categories tracked by the Labor Department, and ranked from the occupations that the foreign-born are least likely to hold, to those jobs they are most likely to occupy, as well as a look at some of the faces of the foreign-born workforce.
22. Law
In 2018, 0.6 percent of foreign-born workers had jobs in the legal field: lawyers, judges and law clerks, among them.
Paying it forward
Negar "Natalie" Ghayoumi is a Iranian-born lawyer who's based in Riverside, California. As featured in the CBSN Originals documentary, "Border Business: Inside Immigration," Ghayoumi focuses on immigration cases -- something she says is common among lawyers who are themselves foreign-born.
21. First responders (tie)
About 0.9 percent of foreign-born workers held jobs in protective services — police officers, firefighters, animal control workers and security guards.
In the line of duty
Houston police chief Art Acevedo, pictured, immigrated to the United States from Cuba. He previously led the Austin, Texas, police department, and served with the California Highway Patrol.
21. Community and social service (tie)
About 0.9 percent of the foreign-born workforce had jobs as social workers, counselors and clergy members.
Trendline
According to a 2019 survey commissioned by the U.S. Conference of Catholic Bishops, 25 percent of newly ordained U.S. priests are foreign-born, with the largest percents hailing from Mexico (5 percent) and Nigeria (3 percent).
19. Scientists
An estimated 1.2 percent of foreign-born workers held science occupations such as biologists, physicists, chemists and economists.
Scientific fact
Notable foreign-born U.S. scientists include Rainer Weiss, pictured, a Nobel Prize-winning physicist whose German family fled Nazi rule in the 1930s.
Public opinion
According to a Pew Research Center survey released in 2019, 78 percent of U.S. adults say they support the immigration of highly skilled workers, such as those with STEM degrees.
18. Athletes, entertainers, artists
In 2018, 1.4 percent of foreign-born workers held jobs in the arts, design, entertainment, sports and media fields. Think actors, singers, designers, pro athletes and news reporters.
Spanning the globe
At the start of the 2018-2019 NBA season, the league reported, there were 108 foreign-born players on opening-night rosters. The numbers included the Phildelphia 76ers' Ben Simmons, pictured, who hails from Australia, and the Milwaukee Bucks' Giannis Antetokounmpo, who was born and raised in Greece.
Canadian country
Grammy-winning superstar Shania Twain, pictured in concert in Los Angeles in 2018, is another example of a foreign-born worker in the arts field. The Canadian singer is scheduled to begin her latest Las Vegas residency in December 2019 at Planet Hollywood Resort & Casino.
17. Farmers, fishermen and foresters
In 2018, 1.6 percent of foreign-born workers held farming, fishing, and forestry jobs, a category which includes animal breeders, loggers and hunters.
16. Architects and engineers
An estimated 2.2 percent of the foreign-born worked in architecture and engineering.
World-building
Mohamad Hafez, seen here in New York City in 2018, is a Syrian-born, Connecticut-based architect. His miniatures tell the story of his war-ravaged homeland.
15. Health-care support
Roughly 2.7 percent of foreign-born workers had health-care support occupations, such as nurses' aides and medical assistants.
14. Mechanics and technicians
In 2018, 2.9 percent of foreign-born workers got their hands dirty in maintenance and repair occupations: car and plane mechanics, power-line installers and locksmiths.
13. Teachers and librarians (tie)
About 3.7 percent of the foreign-born worked in education, including special-education teachers, museum curators and college professors.
Campus VIP
Canadian-born Shirley M. Tilghman, pictured, is a professor of molecular biology and public affairs at Princeton University, where she served as its president from 2001 to 2013.
13. Accountants and financial experts (tie)
An estimated 3.7 percent of foreign-born workers held business and financial jobs, as, say, auditors, tax preparers and real-estate appraisers.
11. Personal-care services
A reported 4.8 percent of the foreign-born worked in personal care and service jobs, including personal trainers, childcare workers and hairstylists.
Stylin'
A-list hairstylist Adir Abergel, pictured, immigrated to the United States from Israel. His client list includes Kristen Stewart and Jennifer Garner.
10. Programmers and mathematicians
An estimated 5.1 percent of the foreign-born worked in computer and math fields. Think web developers, computer programmers and statisticians.
Crunching more numbers
According to a 2018 analysis, 40 percent of Seattle's 143,000-strong civilian IT labor force was foreign-born.
9. Health-care specialists
A reported 5.4 percent of foreign-born workers manned the health-care field as physicians, paramedics, dentists, therapists and pharmacists.
8. Food-service industry
About 6.7 percent of the foreign-born worked in the food-service business, as cooks, waitstaff, bartenders, dishwashers, baristas and chefs.
Kitchen star
Famed chef, author and restaurateur Lidia Bastianich immigrated to the United States from Italy. She has operated her flagship Italian restaurant, Felidia, in New York City since 1981.
7. Administrative workers
Roughly 7.2 percent of foreign-born workers held office-support jobs, which include bank tellers, postal workers, receptionists and bookkeepers.
6. Production workers
A reported 7.4 percent of foreign-born workers labored in production, as butchers, shoe repairers, tailors, woodworkers and bakers.
5. Transportation workers
An estimated 7.6 percent of foreign-born workers held transportation jobs, as pilots, flight attendants, air-traffic controllers, railroad conductors and taxi drivers.
4. Salespeople
A reported 7.7 percent of foreign-born workers held sales-related occupations, including cashiers, travel agents and telemarketers.
3. Maintenance workers
About 8.2 percent of the foreign-born workers toiled in the maintenance field, which includes maids, janitors and landscapers.
2. Managers
About 8.5 percent of foreign-born workers held positions as managers, a job classification that includes sales managers and elected officials, such as Illinois U.S. Rep Raja Krishnamoorthi, pictured, who was a baby when his family immigrated to the United States from India.
Leaders
CEOs are also included in the managers job classification. Foreign-born U.S. CEOs include Sergey Brin, pictured here in 2018. The Google co-founder was born in Russia.
1. Construction workers
About 9.5 percent of foreign-born workers held construction jobs, which include electricians, roofers and carpenters.